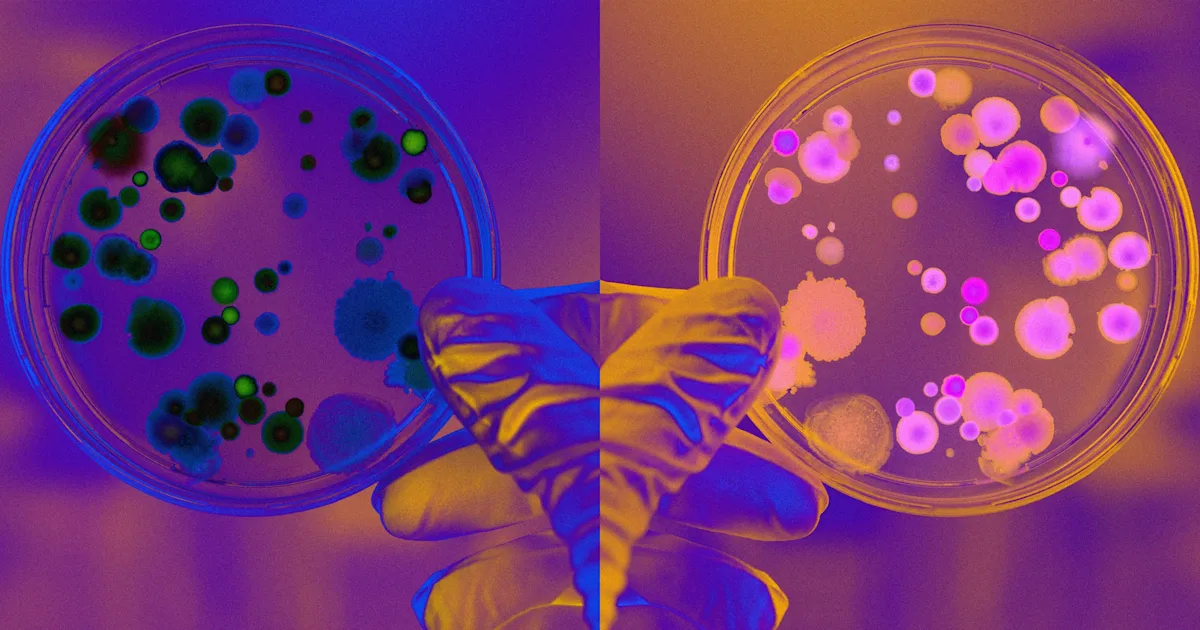
Featured image for Scientists Debate Ceasing Potentially Catastrophic Research

Engineered Microbes Target Tumors by Colonizing Oxygen-Starved Cores
Researchers at the University of Waterloo are engineering Clostridium sporogenes bacteria to invade oxygen-poor tumor cores and consume nutrients from inside, potentially destroying tumors. They added an oxygen-tolerance gene and use quorum sensing to activate it only after enough bacteria accumulate, limiting safety risks. Next steps combine both features in a single strain and test in preclinical trials, showcasing interdisciplinary synthetic-biology cancer research.